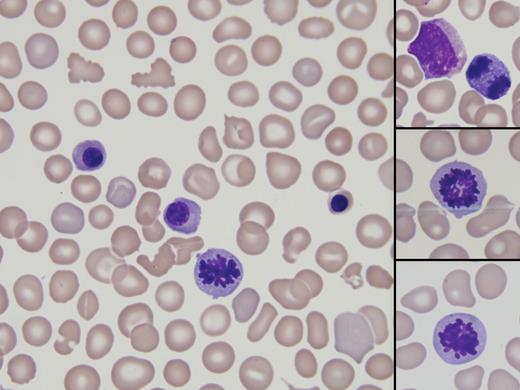
A male neonate was born at 28 weeks of gestational age by C-section because of intrauterine growth restriction and fetal anomalies. Radiographic scans showed cardiomegaly, pleural effusion, and ascites, consistent with hydrops fetalis. He developed a disseminated rash, respiratory failure, anemia, and thrombocytopenia. A complete blood count showed corrected white blood cell count 9.3 × 109/L, hemoglobin 112 g/L, platelets 16 × 109/L, MCV 139.1 fL (normocytic for gestational age), and 353 nucleated red blood cells per 100 white blood cells counted. Morphologic examination of the peripheral blood noted erythroid precursors at every stage of development, as well as a few circulating mitotic figures (see photos). An evaluation for hemolytic disease of the newborn (HDN) was negative. / The baby died 1 day after birth because of extreme prematurity and hyaline membrane disease despite maximal respiratory support. Viral culture of the amniotic fluid was positive for cytomegalovirus (CMV). Autopsy findings confirmed widespread CMV infection, suggestive of CMV-associated hydrops fetalis. / CMV is a common cause of congenital infections, and is associated with extensive neurodevelopmental morbidity in newborns. However, hydrops fetalis is a rare complication of CMV.

A male neonate was born at 28 weeks of gestational age by C-section because of intrauterine growth restriction and fetal anomalies. Radiographic scans showed cardiomegaly, pleural effusion, and ascites, consistent with hydrops fetalis. He developed a disseminated rash, respiratory failure, anemia, and thrombocytopenia. A complete blood count showed corrected white blood cell count 9.3 × 109/L, hemoglobin 112 g/L, platelets 16 × 109/L, MCV 139.1 fL (normocytic for gestational age), and 353 nucleated red blood cells per 100 white blood cells counted. Morphologic examination of the peripheral blood noted erythroid precursors at every stage of development, as well as a few circulating mitotic figures (see photos). An evaluation for hemolytic disease of the newborn (HDN) was negative.
The baby died 1 day after birth because of extreme prematurity and hyaline membrane disease despite maximal respiratory support. Viral culture of the amniotic fluid was positive for cytomegalovirus (CMV). Autopsy findings confirmed widespread CMV infection, suggestive of CMV-associated hydrops fetalis.
CMV is a common cause of congenital infections, and is associated with extensive neurodevelopmental morbidity in newborns. However, hydrops fetalis is a rare complication of CMV.
A male neonate was born at 28 weeks of gestational age by C-section because of intrauterine growth restriction and fetal anomalies. Radiographic scans showed cardiomegaly, pleural effusion, and ascites, consistent with hydrops fetalis. He developed a disseminated rash, respiratory failure, anemia, and thrombocytopenia. A complete blood count showed corrected white blood cell count 9.3 × 109/L, hemoglobin 112 g/L, platelets 16 × 109/L, MCV 139.1 fL (normocytic for gestational age), and 353 nucleated red blood cells per 100 white blood cells counted. Morphologic examination of the peripheral blood noted erythroid precursors at every stage of development, as well as a few circulating mitotic figures (see photos). An evaluation for hemolytic disease of the newborn (HDN) was negative.
The baby died 1 day after birth because of extreme prematurity and hyaline membrane disease despite maximal respiratory support. Viral culture of the amniotic fluid was positive for cytomegalovirus (CMV). Autopsy findings confirmed widespread CMV infection, suggestive of CMV-associated hydrops fetalis.
CMV is a common cause of congenital infections, and is associated with extensive neurodevelopmental morbidity in newborns. However, hydrops fetalis is a rare complication of CMV.
For additional images, visit the ASH IMAGE BANK, a reference and teaching tool that is continually updated with new atlas and case study images. For more information visit http://imagebank.hematology.org.